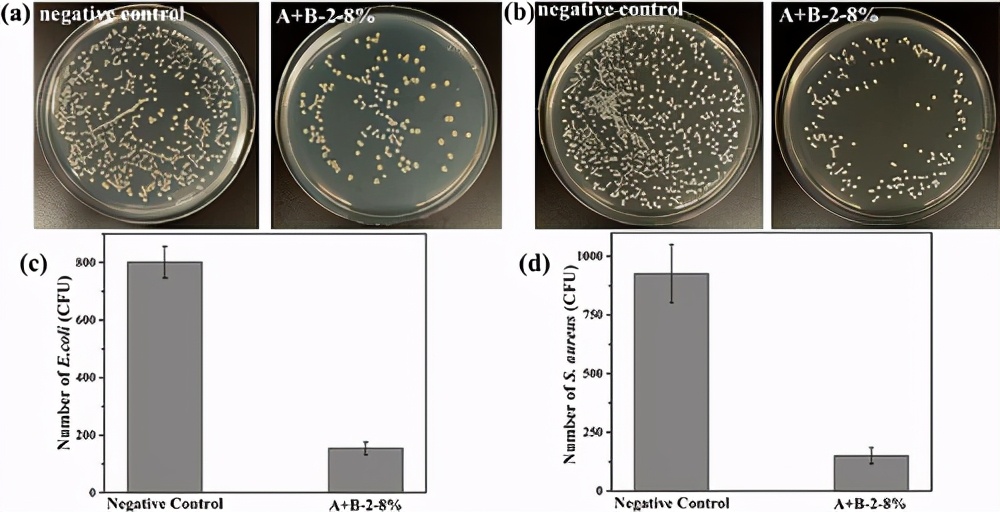
吉林大学史作森/崔占臣:可注射/自愈/抗菌特性的双交联水凝胶

helfet试验

检测生物组织中的糖类,脂肪和蛋白质1_必修一课件ppt
图片尺寸1080x810
1《植物生长素的发现》课件(新人教版必修3)ppt
图片尺寸1080x810
高考生物考点复习植物的激素调节的理解和应用
图片尺寸663x427
夫兰克—赫兹实验xppt
图片尺寸1080x810
israeli researchers develop method for 30-second b
图片尺寸974x650
2016届高中生物一轮复习植物激素调节microsoft office
图片尺寸1080x810
植物生长激素的发现ppt
图片尺寸1080x810
生物必修一 实验:检测生物组织中的糖类_脂肪和蛋白质ppt
图片尺寸1080x810
吉林大学史作森/崔占臣:可注射/自愈/抗菌特性的双交联水凝胶
图片尺寸1000x512
hospital group recommends self-swabbing to increas
图片尺寸2133x1425
5.1光合作用吸收二氧化碳释放氧(二)ppt
图片尺寸1080x810
development and evaluation of serotype-specific reco
图片尺寸785x493
3.5.1光合作用吸收二氧化碳释放氧气(课改精品课件)ppt
图片尺寸1080x810
现有①液氧②液态空气③冰水共存物④二氧化锰⑤食盐
图片尺寸410x173
代谢学人sciencetranslationalmedicinehif1α抑制剂px47
图片尺寸788x977
而这些,都是碰撞试验假人无法完
图片尺寸1080x717
mir6224 may be a negative regulator of menin in lung cancer
图片尺寸2031x2837
coombs test
图片尺寸1903x1780
初筛实验图片
图片尺寸639x371
srm耳石全自动诊疗系统
图片尺寸2000x2000